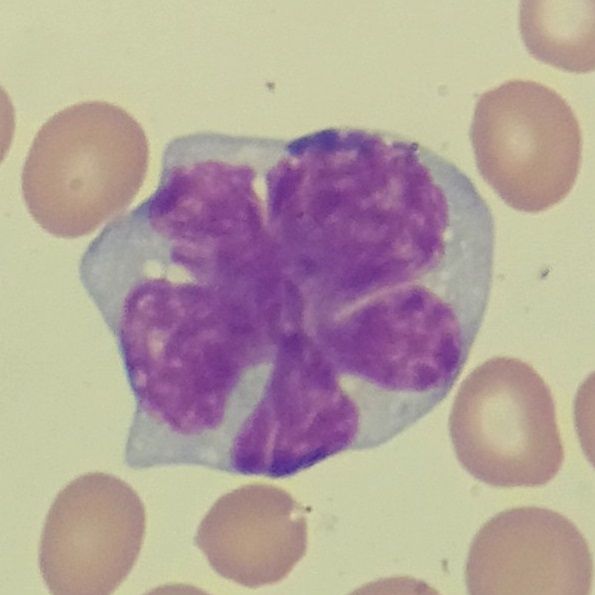

Retrospective data encourage further exploration of non-ASCT regimens in younger patients with mantle cell lymphoma, while maintenance rituximab should be considered following first-line therapy with bendamustine plus rituximab.
Findings from large retrospective real-world cohorts indicate that 1 in 4 young patients with mantle cell lymphoma (MCL) received cytarabine or autologous stem cell transplantation (ASCT), highlighting a need for therapies that can be administered effectively in clinical practice according to data from a retrospective, real-world study published in the Journal of Clinical Oncology.
"There should be a continuous focus on the development of treatments that can be effectively delivered and implemented in routine and community practices,” according to the authors of a study published in the Journal of Clinical Oncology.
Between 2011 and 2020, patients younger than 65 years old (n = 1265) most commonly received cytarabine-containing induction regimens (30.5%) followed by bendamustine plus rituximab (Rituxan; 28.0%), and rituximab plus cyclophosphamide, doxorubicin, vincristine, and prednisone (R-CHOP; 21.1%). Additionally, 23.5% of patients received ASCT and 20.9% received maintenance rituximab.
Investigators identified no significant association between receipt of ASCT and real-world time to next treatment (TTNT; HR, 0.84; 95% CI, 0.68-1.03; P = .10), as well as overall survival (OS; HR, 0.86; 95% CI, 0.63-1.18; P = .4) for ASCT-eligible patients. The 3-year real-world TTNT rate was 65% (95% CI, 59%-71%) for those who received ASCT vs 59% (95% CI, 55%-64%) for those who did not receive ASCT. Additionally, the 3-year OS rate in each respective group was 88% (95% CI, 83%-92%) vs 84% (95% CI, 81%-88%).
“There should be a continuous focus on the development of treatments that can be effectively delivered and implemented in routine and community practices,” the study authors stated. “Second, our data suggest that the risk/benefit ratio of ASCT should be carefully weighed for each patient and it may be reasonable to perform future trials without a requirement for ASCT in younger patients.”
Among patients eligible to receive maintenance rituximab, treatment with the agent following bendamustine plus rituximab correlated with significantly longer real-world TTNT (HR, 1.96; 95% CI, 1.61-2.38; P <.001) and OS (HR, 1.51; 95% CI, 1.19-1.92; P <.001) compared with bendamustine plus rituximab alone. The 3-year real-world TTNT rate was 74% (95% CI, 70%-79%) for patients receiving maintenance rituximab vs 51.0% (95% CI, 46%-56%) for those who only received bendamustine plus rituximab. Additionally, the 3-year OS rate in each respective group was 84% (95% CI, 80%-88%) vs 74% (95% CI, 70%-79%).
“Furthermore, the substantial survival benefit achieved with [maintenance rituximab] in patients responding to [first-line bendamustine plus rituximab], a frequently used chemoimmunotherapy regimen, should be considered routinely in patients with MCL,” the study authors stated.
Investigators of this study collected retrospective data from the Flatiron Health electronic database on 4216 patients diagnosed with MCL between 2011 and 2021. Most patients received treatment in community clinics not affiliated with teaching institutions. The validation cohort included 1168 patients who received treatment across 12 academic centers.
End points in the Flatiron cohort included real-world TTNT, defined as the time from start of first-line treatment to subsequent therapy or death, and OS. End points in the validation cohort included progression-free survival (PFS) and OS.
Patients 18 years or older with a confirmed MCL diagnosis and at least 2 clinic visit records were included in the Flatiron cohort. In the validation cohort, investigators included patients who had disease control after induction treatment and were eligible to receive ASCT and maintenance rituximab in clinical trials and routine practice.
Among evaluable patients in the Flatiron cohort (n = 3614), the median age was 69.4 years (range, 27.7-84.6) and 87% received treatment in a community oncology setting. The most frequent induction regimens administered to patients younger than 65 years old (n = 287) and those 65 years and older (n = 2329) before ASCT, respectively, included R-CHOP (21.3% and 15.2%) and bendamustine plus rituximab (19.2% and 49.0%).
In the validation cohort, the median patient age was 62 years. Additionally, 47% of patients younger than 65 years old in the validation cohort received ASCT.
The median real-world TTNT in the first-line MCL Flatiron cohort was 24.0 months (95% CI, 21.9-26.2), and the 3-year OS rate was 68% (95% CI, 66%-69%). The median real-world TTNT was 34.4 months (95% CI, 31.1-37.9) for patients receiving bendamustine plus rituximab, 31.0 months (95% CI, 24.2-41.7) for those receiving cytarabine-based regimens, and 16.0 months (95% CI, 13.2-19.0) for those receiving R-CHOP. Additionally, the 3-year OS rate in each respective treatment group was 68% (95% CI, 66%-71%), 73% (95% CI, 68%-77%), and 74% (95% CI, 70%-77%).
Among maintenance rituximab-eligible patients in the validation cohort (n = 258), the 3-year PFS rate was 74.2% (95% CI, 61.6%-83.2%) for patients receiving bendamustine plus rituximab and maintenance rituximab vs 48.5% (95% CI, 30.5%-64.3%) for patients receiving bendamustine plus rituximab alone. The 3-year OS rate in each respective treatment group was 91.9% (95% CI, 81.6%-96.5%) vs 73.2% (95 CI, 53.7%-85.5%).
Among patients eligible for ASCT in the validation cohort (n = 511), the 3-year PFS rate was 69.6% (95% CI, 63.6%-74.8%) for those receiving ASCT vs 69.0% (95% CI, 61.2%-75.6%) for those who did not receive ASCT.
Martin P, Cohen JB, Wang M, et al. Treatment outcomes and roles of transplantation and maintenance rituximab in patients with previously untreated mantle cell lymphoma: results from large real-world cohorts. J Clin Oncol. 2023;41(3):541-554. doi:10.1200/JCO.21.02698
Highlighting Insights From the Marginal Zone Lymphoma Workshop
Clinicians outline the significance of the MZL Workshop, where a gathering of international experts in the field discussed updates in the disease state.